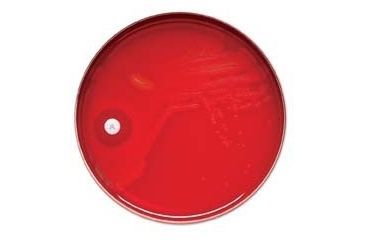
Image of BD Taxo P Discs for Differentiation of Pneumococci, BD Diagnostic Systems 231554

Tap Tap to Zoom
Code: B4-9NH-231554
MPN: 231554
Product Info for BD Taxo P Discs for Differentiation of Pneumococci, BD Diagnostic Systems 231554
BD Taxo P Discs for Differentiation of Pneumococci, BD Diagnostic Systems is a reliable and dependable addition to the BD Laboratory Media family of products. Combining top-notch and uncompromising quality with an affordable price, the BD Taxo P Discs for Differentiation of Pneumococci, BD Diagnostic Systems 231554/ 90002-338 can fulfill your laboratory needs while still offering a great value for the money.![]()
Product Category Description:
These discs are recommended for use with pure cultures in the presumptive identification of pneumococci. The 6mm dia. (1/4") discs are made from high quality absorbent paper that has been impregnated with approximately 5µg ethylhydrocupreine hydrochloride (optochin), which markedly inhibits the growth of pneumococci, but not of other streptococci. Pneumococci can, therefore, be differentiated from other alpha-hemolytic streptococci by the formation of a zone of inhibition around a disc placed on a blood agar plate heavily inoculated with a pure culture suspected to be Streptococcus pneumoniae. (BD 231554)
Ordering Information: Packaged 50 discs per cartridge, 10 cartridges per pack. The last disc in each cartridge is marked with an “X” and contains the agent as coded.
Specifications for BD Taxo P Discs for Differentiation of Pneumococci, BD Diagnostic Systems 231554 :
| Description: | TAXO P PK-10 CART | |
BD Taxo P Discs for Differentiation of Pneumococci, BD Diagnostic Systems 231554 Orderable Models
List of Orderable Models
- BD Taxo P Discs for Differentiation of Pneumococci, BD Diagnostic Systems 231554 , MPN: 231554 , Code: B4-9NH-231554